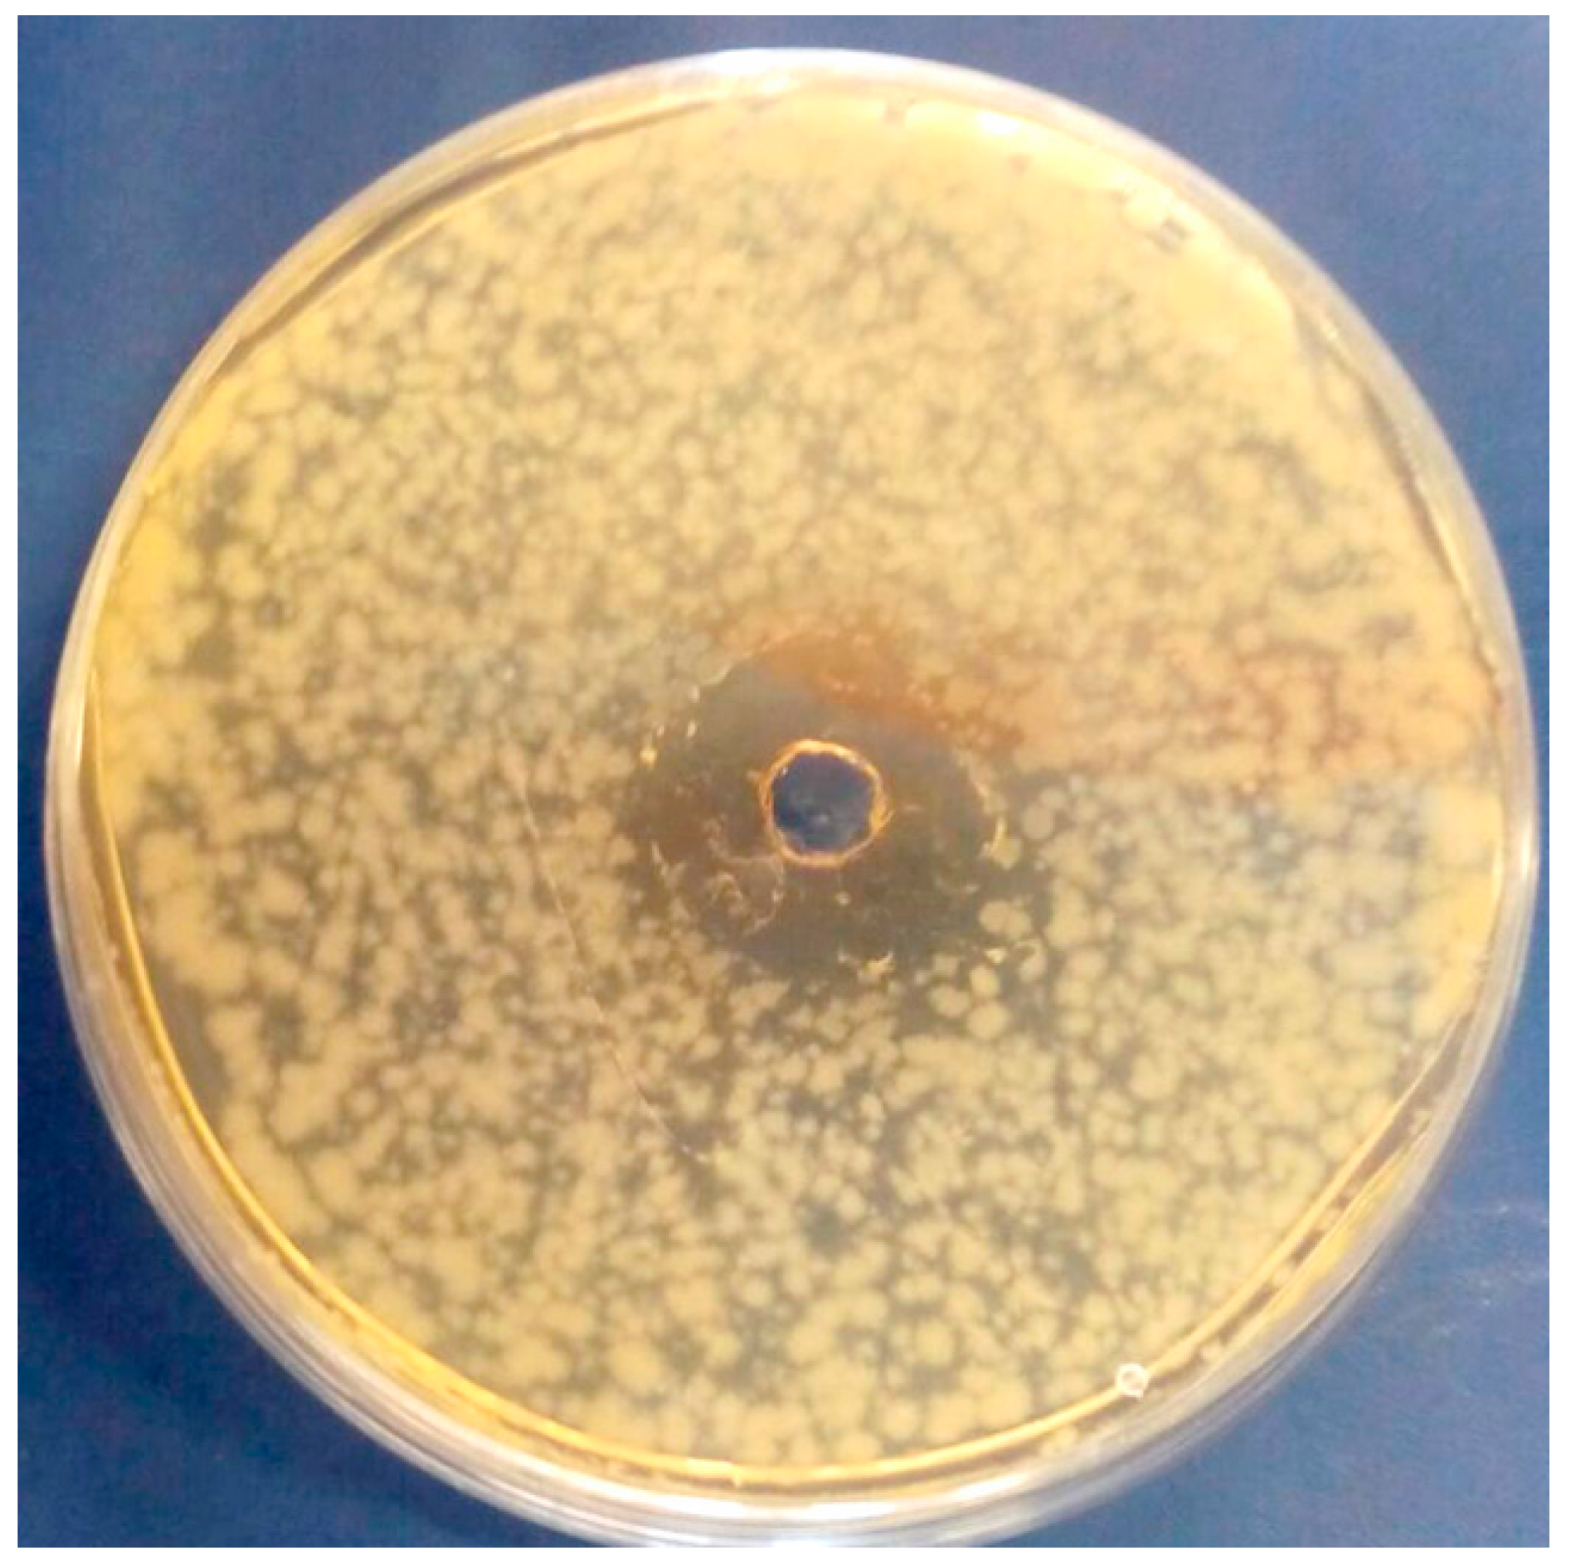
Antioxidants 08 00255 g003

Addition of Olive Leaf Extract (OLE) for Producing Fortified Fresh Pasteurized Milk with an Extended Shelf Life
Abstract
:1. Introduction
2. Materials and Methods
2.1. Olive Leaf Extract Preparation
2.2. Chemicals and Reagents
2.3. Qualitative and Quantitative Determination of OLE Polyphenols by HPLC/DAD and HPLC/ESI-MS
2.4. Antioxidant Capacity of OLE
2.5. In Vitro Inhibition of α-Glucosidase Activity and IC50 Determination
2.6. In Vitro Evaluation of OLE Antimicrobial Activity
2.7. Preparation of OLE-Enriched Milk
2.8. Antimicrobial Activity of OLE on Whole Pasteurized Milk
2.9. Compositional and Color Analysis of Milk Samples Enriched with OLE
2.10. Sensory Analysis
2.11. Statistical Analysis
3. Results and Discussion
3.1. Identification of OLE Polyphenols
3.2. Antioxidant Activity of Olive Leaves Extract
3.3. Inhibition of α-Glucosidase
3.4. In Vitro Antibacterial Activity of OLE
3.5. Antimicrobial Effect of OLE on Milk Samples
3.6. Determination of Principal Compositional Parameters of OLE-Enriched Milk
3.7. Color
3.8. Impact of OLE Addition on Liking
4. Conclusions
Author Contributions
Funding
Conflicts of Interest
References
- Anema, K.G. Storage stability and age gelation of reconstituted ultra-high temperature skim milk. Int. Dairy J. 2017, 75, 56–67. [Google Scholar] [CrossRef]
- Malmgren, B.; Ardö, Y.; Langton, M.; Altskär, A.; Bremer, M.G.E.G.; Dejmek, P.; Paulsson, M. Changes in proteins, physical stability and structure in directly heated UHT milk during storage at different temperatures. Int. Dairy J. 2017, 71, 60–75. [Google Scholar] [CrossRef]
- Perkins, M.L.; D’Arcy, B.R.; Lisle, A.T.; Deeth, H.C. Solid phase microextraction of stale flavour volatiles from the headspace of UHT milk. J. Sci. Food Agric. 2005, 85, 2421–2428. [Google Scholar] [CrossRef]
- Machado, S.G.; Bagliniere, F.; Marchand, S.; Van Coillie, E.; Vanetti, M.C.D.; De Block, J.; Heyndrickx, M. The biodiversity of the microbiota producing heatresistant enzymes responsible for spoilage in processed bovine milk and dairy products. Front. Microbiol. 2017, 8, 302–324. [Google Scholar] [CrossRef] [PubMed]
- Tassou, C.C.; Nychas, G.J.E.; Board, R.G. Effect of phenolic-compounds and oleuropein on the germination of Bacillus-cereus t-spores. Biotechnol. Appl. Biochem. 1991, 13, 231–237. [Google Scholar] [PubMed]
- Serra, A.T.; Matias, A.A.; Nunes, A.V.M.; Leitao, M.C.; Brito, D.; Bronze, R.; Silva, S.; Pires, A.; Crespo, M.T.; Romao, M.V.S.; et al. In vitro evaluation of olive- and grape-based natural extracts as potential preservatives for food. Innov. Food Sci. Emerg. Technol. 2008, 9, 311–319. [Google Scholar] [CrossRef]
- Gok, V.; Bor, Y. Effect of olive leaf, blueberry and Zizyphus jujuba extracts on the quality and shelf life of meatball during storage. J. Food Agric. Environ. 2012, 10, 190–195. [Google Scholar]
- Albertos, I.; Avena-Bustillos, R.J.; Martín-Diana, A.B.; Du, W.-X.; Rico, D.; McHugh, T.H. Antimicrobial olive leaf gelatin films for enhancing the quality of cold smoked Salmon. Ind. Crop. Prod. 2017, 94, 800–811. [Google Scholar] [CrossRef]
- Thielmann, J.; Kohnen, S.; Hauser, C. Antimicrobial activity of Olea europaea Linné extracts and their applicability as natural food preservative agents. Int. J. Food Microbiol. 2017, 251, 48–66. [Google Scholar] [CrossRef]
- Talhaoui, N.; Taamalli, A.; Gómez-Caravaca, A.M.; Fernández-Gutiérrez, A.; Segura-Carretero, A. Phenolic compounds in olive leaves Analytical determination, biotic and abiotic influence, and health benefits. Food Res. Int. 2015, 77, 92–108. [Google Scholar] [CrossRef]
- Palmeri, R.; Monteleone, J.I.; Spagna, G.; Restuccia, C.; Raffaele, M.; Vanella, L.; Li Volti, G.; Barbagallo, I. Olive leaf extract from Sicilian cultivar reduced lipid accumulation by inducing thermogenic pathway during adipogenesis. Front. Pharmacol. 2016, 7, 143–153. [Google Scholar] [CrossRef] [PubMed]
- Barbagallo, I.; Li Volti, G.; Raffaele, M.; Distefano, A.; Palmeri, R.; Parafati, L.; Licari, M.; Zingales, V.; Avola, R.; Vanella, L. The effects of olive leaf extract from a Sicilian cultivar in an experimental model of hepatic steatosis. Rendiconti Lincei. Scienze Fisiche e Naturali 2017, 4, 643–650. [Google Scholar] [CrossRef]
- Qabaha, K.; Al-Rimawi, F.; Qasem, A.; Naser, S.A. Oleuropein is responsible for the major anti-inflammatory effects of olive leaf extract. J. Med. Food 2018, 21, 302–305. [Google Scholar] [CrossRef] [PubMed]
- Hadrich, F.; Bouallagui, Z.; Junkyu, H.; Isoda, H.; Sayadi, S. The α-glucosidase and α- amylase enzyme inhibitory of hydroxytyrosol and oleuropein. J. Oleo Sci. 2015, 64, 835–843. [Google Scholar] [CrossRef] [PubMed]
- Gambacorta, G.; Faccia, M.; Previtali, M.A.; Pati, S.; La Notte, E.; Baino, A. Effect of olive maturation and stoning on quality indices and antioxidant content of extra virgin olive oil (cv. Coratina) during storage. J. Food Sci. 2010, 75, 229–235. [Google Scholar] [CrossRef]
- Brand-Williams, W.; Cuvelier, M.-E.; Berset, C. Use of a free radical method to evaluate antioxidant activity. LWT—Food Sci. Technol. 1995, 28, 25–30. [Google Scholar] [CrossRef]
- Jabeen, F.; Oliferenko, P.V.; Oliferenko, A.A.; Pillai, G.G.; Ansari, F.L.; Hall, C.D.; Katritzky, A.R. Dual inhibition of the α-glucosidase and butyrylcholinesterase studied by Molecular Field Topology Analysis. Eur. J. Med. Chem. 2014, 80, 228–242. [Google Scholar] [CrossRef] [PubMed]
- AOAC. Official Methods of Analysis, 16th ed.; Association of Official Analytical Chemists: Washington, DC, USA, 1998. [Google Scholar]
- Triebold, H.O. Chapter XII. Quantitative Analysis with Applications to Agricultural and Food Products, 2nd ed.; D. van Nostrand Company Inc.: New York, NY, USA, 2000. [Google Scholar]
- UNI EN ISO 8589. Sensory analysis—General guidance for the design of test rooms. 2014. Available online: https://www.saiglobal.com/pdftemp/previews/osh/iso/data/poddata/000/718/718162. (accessed on 30 July 2019).
- Souilem, S.; Fki, I.; Kobayashi, I.; Khalid, N.; Neves, M.; Isoda, H.; Sayadi, S.; Nakajima, M. Emerging technologies for recovery of value-added components from olive leaves and their applications in food/feed industries. Food Bioproc. Tech. 2017, 10, 229–248. [Google Scholar] [CrossRef]
- Palmeri, R.; Restuccia, C.; Monteleone, J.I.; Sperlinga, E.; Siracusa, L.; Serafini, M.; Finamore, A.; Spagna, G. Bioactivity improvement of Olea europaea leaf extract biotransformed by Wickerhamomyces anomalus enzymes. Plant Foods Hum. Nutr. 2017, 72, 211–218. [Google Scholar] [CrossRef]
- Ben Salah, M.; Abdelmelek, H.; Abderraba, M. Study of Phenolic Composition and Biological Activities Assessment of Olive Leaves from different Varieties Grown in Tunisia. Med. Chem. 2012, 2, 107–111. [Google Scholar] [CrossRef]
- Petridis, A.; Therios, I.; Samouris, G.; Koundouras, S.; Giannakoula, A. Effect of water deficit on leaf phenolic composition, gas exchange, oxidative damage and antioxidant activity of four Greek olive (Olea europaea L.) cultivars. Plant Physiol. Biochem. 2012, 60, 1–11. [Google Scholar] [CrossRef] [PubMed]
- Irakli, M.; Chatzopoulou, P.; Ekateriniadou, L. Optimization of ultrasound-assisted extraction of phenolic compounds:Oleuropein, phenolic acids, phenolic alcohols and flavonoids from olive leaves and evaluation of its antioxidant activities. Ind. Crops Prod. 2018, 124, 382–388. [Google Scholar] [CrossRef]
- Edziri, H.; Jaziri, R.; Chehab, H.; Verschaeve, L.; Flamini, G.; Boujnah, D.; Hammami, M.; Aouni, M.; Mastouri, M. A comparative study on chemical composition, antibiofilm and biological activities of leaves extracts of four Tunisian olive cultivars. Heliyon 2019, 5, 1604–1612. [Google Scholar] [CrossRef] [PubMed]
- Olmo-García, L.; Bajoub, A.; Benlamaalam, S.; Hurtado-Fernández, E.; Bagur-González, M.G.; Chigr, M.; Mohamed Mbarki, M.; Fernández-Gutiérrez, A.; Carrasco-Pancorbo, A. Establishing the phenolic composition of Olea europaea L. leaves from cultivars grown in Morocco as a crucial step towards their subsequent exploitation. Molecules 2018, 23, 2524. [Google Scholar] [CrossRef] [PubMed]
- Romani, A.; Mulas, S.; Heimler, D. Polyphenols and secoiridoids in raw material (Olea europaea L. leaves) and commercial food supplements. Eur. Food Res. Technol. 2017, 243, 429–435. [Google Scholar] [CrossRef]
- Dekdouk, N.; Malafronte, N.; Russo, D.; Faraone, I.; De Tommasi, N.; Ameddah, S.; Severino, L.; Milella, L. Phenolic compounds from Olea europea L. possess antioxidant activity and inhibit carbohydrate metabolizing enzymes in vitro. Evid. Based Complement. Alternat. Med. 2015, 2015, 684925–684934. [Google Scholar] [CrossRef]
- Yin, Z.; Zhang, W.; Feng, F.; Zhang, Y.; Kang, W. α-Glucosidase inhibitors isolated from medicinal plants. Food Sci. Hum. Wellness 2014, 3, 136–174. [Google Scholar] [CrossRef]
- Nyambe-Silavwe, H.; Williamson, G. Polyphenol- and fibre-rich dried fruits with green tea attenuate starch-derived postprandial blood glucose and insulin: A randomised, controlled, single-blind, cross-over intervention. Br. J. Nutr. 2016, 116, 443–450. [Google Scholar] [CrossRef]
- Doan, H.V.; Riyajan, S.; Iyara, R.; Chudapongse, N. Antidiabetic activity, glucose uptake stimulation and α-glucosidase inhibitory effect of Chrysophyllum cainito L. stem bark extract. BMC Complement. Altern. Med. 2018, 18, 267. [Google Scholar] [CrossRef]
- Pereira, A.; Ferreira, I.; Marcelino, F.; Valentão, P.; Andrade, P.B.; Seabra, R. Phenolic compounds and antimicrobial activity of olive (Olea europaea L. Cv. Cobranc¸ osa) leaves. Molecules 2007, 12, 1153–1162. [Google Scholar] [CrossRef]
- Tuncel, G.; Nergiz, C. Antimicrobial effect of some olive phenols in a laboratory medium. Lett. Appl. Microbiol. 1993, 17, 300–302. [Google Scholar] [CrossRef]
- COUNCIL DIRECTIVE 92/46/EEC of 16 June 1992 Laying Down the Health Rules for the Production and Placing on the Market of Raw Milk, Heat Treated Milk and Milk-Based Products. Off. J. Eur. Communities. 1992. Available online: https://eur-lex.europa.eu/legal-content/EN/TXT/?uri=OJ:L:1992:268:TOC (accessed on 30 July 2019).
- Moore, K.L.; Patel, J.; Jaroni, D.; Friedman, M.; Ravishankar, S. Antimicrobial activity of apple, hibiscus, olive, and hydrogen peroxide formulations against Salmonella enterica on organic leafy greens. J. Food Prot. 2011, 74, 1676–1683. [Google Scholar] [CrossRef] [PubMed]
- Moudache, M.; Colon, M.; Nerin, C.; Zaidi, F. Phenolic content and antioxidant activity of olive by-products and antioxidant film containing olive leaf extract. Food Chem. 2016, 212, 521–527. [Google Scholar] [CrossRef] [PubMed]
- Johnston, D.W.; Bruce, J. Incidence of thermo duric psychrotrophs in milk produced in West Scotland. J. Appl. Bacteriol. 1982, 52, 333–337. [Google Scholar] [CrossRef] [PubMed]
- Hayes, J.E.; Stepanyan, V.; Allen, P.; O’Grady, M.N.; Kerry, J.P. Effect of lutein, sesamol, ellagic acid and olive leaf extract on the quality and shelf-life stability of packaged raw minced beef patties. Meat Sci. 2010, 84, 613–620. [Google Scholar] [CrossRef] [PubMed]
- Moudache, M.; Nerín, C.; Colon, M.; Zaidi, F. Antioxidant effect of an innovative active plastic film containing olive leaves extract on fresh pork meat and its evaluation by Raman spectroscopy. Food Chem. 2017, 229, 98–103. [Google Scholar] [CrossRef]
- Difonzo, G.; Pasqualone, A.; Silletti, R.; Cosmai, L.; Summo, C.; Paradiso, V.M.; Caponio, F. Use of olive leaf extract to reduce lipid oxidation of baked snacks. Food Res. Int. 2018, 108, 48–56. [Google Scholar] [CrossRef]
- Capodifoglio, E.; Vidal, A.M.C.; Lima, J.A.S.; Bortoletto, F.; D’Abreu, L.F.; Gonçalves, A.C.S.; Vaz, A.C.N.; Balieiro, J.C.C.; Netto, A.S. Lipolytic and proteolytic activity of Pseudomonas spp. isolated during milking and storage of refrigerated raw milk. J. Dairy Sci. 2016, 99, 5214–5223. [Google Scholar] [CrossRef]
- Popov-Raljić, J.V.; Lakić, N.S.; Laličić-Petronijević, G.J.; Barać, M.B.; Sikimić, V.M. Color changes of UHT milk during storage. Sensors 2008, 8, 5961–5974. [Google Scholar] [CrossRef]
- Bermúdez-Aguirre, D.; Mawson, R.; Versteeg, K.; Barbosa-Cánovas, G.V. Composition properties, physicochemical characteristics and shelf life of whole milk after thermal and thermo-sonication treatments. J. Food Qual. 2007, 32, 283–302. [Google Scholar] [CrossRef]
- Francis, F.J.; Clydesdale, F.M. Food Colorimetry: Theory and Applications; Avi Publishing Co Inc.: Westport, CT, USA, 1975. [Google Scholar]
- Clydesdale, F.M. Color perception and food quality. J. Food Qual. 1991, 14, 61–74. [Google Scholar] [CrossRef]

| Peak | Compound | Rt | Content mg/mL | Content (mg/g dry veg mat) |
|---|---|---|---|---|
| 1 | Hydroxytirosol glucoside | 6.16 | 0.008 | 0.16 |
| 2 | Hydroxytirosol | 6.74 | 0.010 | 0.20 |
| 3 | Dihydroxyphenylacetic acid (DOPAC) | 7.17 | 0.004 | 0.08 |
| 4 | Chlorogenic acid | 9.87 | 0.002 | 0.04 |
| 5 | Caffeic acid | 10.21 | 0.002 | 0.04 |
| 6 | Verbascoside | 12.33 | 0.013 | 0.26 |
| 7 | p-Coumaric acid | 12.43 | 0 | tr |
| 8 | Ferulic acid | 13.03 | 0 | tr |
| 9 | Rutin | 13.39 | 0.016 | 0.31 |
| 10 | Luteolin 7-O-glucoside | 13.48 | 0.040 | 0.81 |
| 11 | Oleuropein | 15.5 | 1.44 | 28.86 |
| 12 | Apigenin 7-O-glucoside | 15.69 | 0.016 | 0.32 |
| 13 | Ligstroside | 16.99 | 0.056 | 1.12 |
| Color Parameters | OLE Content (v/v) | ||||
|---|---|---|---|---|---|
| 0% | 1% | 2% | 5% | ||
| Storage Time 0 (d) | L * | 81.08 ± 0.00 a | 80.93 ± 0.01 b | 80.63 ± 0.00 c | 80.18 ± 0.00 d |
| a * | −2.54 ± 0.00 d | −2.49 ± 0.01 c | −2.41 ± 0.01 b | −2.24 ± 0.01 a | |
| b * | 5.31 ± 0.00 d | 5.40 ± 0.00 c | 5.46 ± 0.01 b | 5.74 ± 0.00 a | |
| C | 5.89 ± 0.00 d | 5.95 ± 0.01 c | 5.97 ± 0.01 b | 6.16 ± 0.01 a | |
| ΔE 0–1% | ΔE 0–2% | ΔE 0–5% | |||
| 0.19 ± 0.01 c | 0.37 ± 0.01 b | 1.04 ± 0.00 a | |||
| Storage Time 6 (d) | L * | 79.11 ± 1.39 a | 79.13 ± 1.53 a | 78.87 ± 1.55 a | 78.05 ± 1.59 a |
| a * | −2.45 ± 0.81 d | −2.32 ± 0.05 c | −2.21 ± 0.03 b | −1.94 ± 0.03 a | |
| b * | 5.07 ± 1.10 b | 5.40 ± 0.13 b | 5.34 ± 0.14 ab | 5.71 ± 0.16 a | |
| C | 4.36 ± 1.29 a | 5.75 ± 0.14 a | 5.78 ± 0.14 a | 6.03 ± 0.16 a | |
| ΔE 0–1% | ΔE 0–2% | ΔE 0–5% | |||
| 1.69 ± 2.28 a | 1.89 ± 2.11 a | 2.59 ± 1.69 a | |||
| Δh 0–6 d | 0.14 ± 0.25 a | 0.02 ± 0.00 a | 0.02 ± 0.00 a | 0.04 ± 0.01 a | |
© 2019 by the authors. Licensee MDPI, Basel, Switzerland. This article is an open access article distributed under the terms and conditions of the Creative Commons Attribution (CC BY) license (http://creativecommons.org/licenses/by/4.0/).
Share and Cite
Palmeri, R.; Parafati, L.; Trippa, D.; Siracusa, L.; Arena, E.; Restuccia, C.; Fallico, B. Addition of Olive Leaf Extract (OLE) for Producing Fortified Fresh Pasteurized Milk with an Extended Shelf Life. Antioxidants 2019, 8, 255. https://doi.org/10.3390/antiox8080255
Palmeri R, Parafati L, Trippa D, Siracusa L, Arena E, Restuccia C, Fallico B. Addition of Olive Leaf Extract (OLE) for Producing Fortified Fresh Pasteurized Milk with an Extended Shelf Life. Antioxidants. 2019; 8(8):255. https://doi.org/10.3390/antiox8080255
Chicago/Turabian StylePalmeri, Rosa, Lucia Parafati, Daniela Trippa, Laura Siracusa, Elena Arena, Cristina Restuccia, and Biagio Fallico. 2019. "Addition of Olive Leaf Extract (OLE) for Producing Fortified Fresh Pasteurized Milk with an Extended Shelf Life" Antioxidants 8, no. 8: 255. https://doi.org/10.3390/antiox8080255





